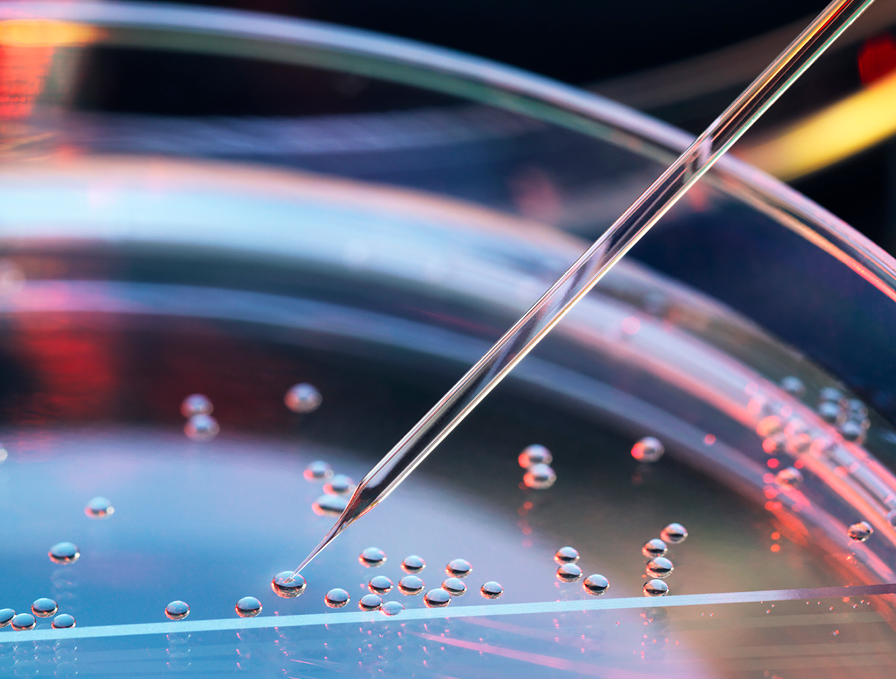

Läkemedel & hälsa
Kantar är experter på rådgivning och beslutsunderlag inom Life Science. Sedan 1985 är vi ledande inom marknadsundersökningar på området hälsa och läkemedel.
Vi använder oss av olika metoder för datainsamling, som till exempel webbenkäter/ onlineundersökningar, telefonintervjuer och digital research, och gör kvalitativa undersökningar med djupintervjuer och fokusgrupper både live, på telefon och digitalt.
Vi hjälper dig med att utvärdera just ditt informationsbehov, och föreslår en lösning som leder till ett konkret beslutsunderlag, rekommendationer och vägledning kring hur er affär ska växa, oavsett var i livscykeln ditt läkemedel befinner sig.
Berätta för oss vad du behöver veta, så berättar vi hur vi kan ta reda på det!
Våra undersökningar
Vi genomför olika standardiserade undersökningar såsom:
- Navigare Sales Force Impact: Share of Voice-mätning som visar hur ditt företag och din säljkår står sig i konkurrensen. Minns läkarna besöken? Vilka besök har störst inverkan?
- Navigare Multichannel Optimization: Utvärdering av olika kommunikationskanaler, både personliga och digitala, och deras genomslagskraft. Vilken kanal uppskattas mest av din kundgrupp? Hur mottagliga är läkarna på ditt område för digital information?
- Navigare Company Image: Fokus på hur läkarna uppfattar ditt företag och varumärke jämfört med konkurrenterna. Vilka styrkor har ni? Vad kan ni jobba vidare på? Vad är viktigast för kunderna?
- Navigare Patient Flow: När i behandlingstrappan kommer ditt biologiska läkemedel in? Vilka andra biologiska läkemedel har patienten använt? Vilka styrkor och svagheter ser läkarna med de biologiska läkemedlen? Undersökning inom reumatologi, dermatologi och IBD med fokus på biologiska läkemedel och JAK-hämmare.
- Navigare Social Media Listening: Vilka diskussioner förs om ditt terapiområde? På vilka plattformar och forum? Vilka är det som diskuterar terapiområdet – patienter, läkare, organisationer? Social Medial Listening ger dig en grundlig genomgång av sociala medier och det innehåll som finns om ett specifikt terapiområde.
Bland studier som designas särskilt för dig finns både standardundersökningar och undersökningar som tas fram och anpassas efter dina specifika behov:
- Share of Voice, Message Recall, kampanjtester
- Market Description, ATU (Awareness, Trial, Usage), Brand Equity, Perceptual mapping
- Olika typer av skräddarsydda undersökningar som passar just dina frågeställningar
Varför Navigare
- Djup insikt: Våra konsulter är specialiserade på marknadsundersökningar inom hälsa och läkemedel och har lång erfarenhet av att bistå läkemedelsbranschen med det beslutsunderlag och rådgivning som behövs för att affärer ska växa.
- Bred tillgång: Vi har tillgång till relevanta respondentgrupper som t.ex. läkare, tandläkare, sjuksköterskor och olika beslutsfattare. Vi har även Sveriges största webbpanel bland allmänheten med cirka 100 000 panelister, där vi kan screena fram diagnoser för patient- och anhörig undersökningar.
- Lång erfarenhet: Ledande på marknadsundersökningar inom Life Science sedan 1985. Under namnet Navigare.
Våra kunder
Våra kunder är stora som små läkemedelsbolag, MedTech-företag, genterapiföretag, tankesmedjor, start-ups och andra företag inom Life Science, likaväl som myndigheter och organisationer.
General Sidebar
Vill du veta mer om hur vi kan hjälpa dig med just dina frågor? Kontakta Lena Berggren här!